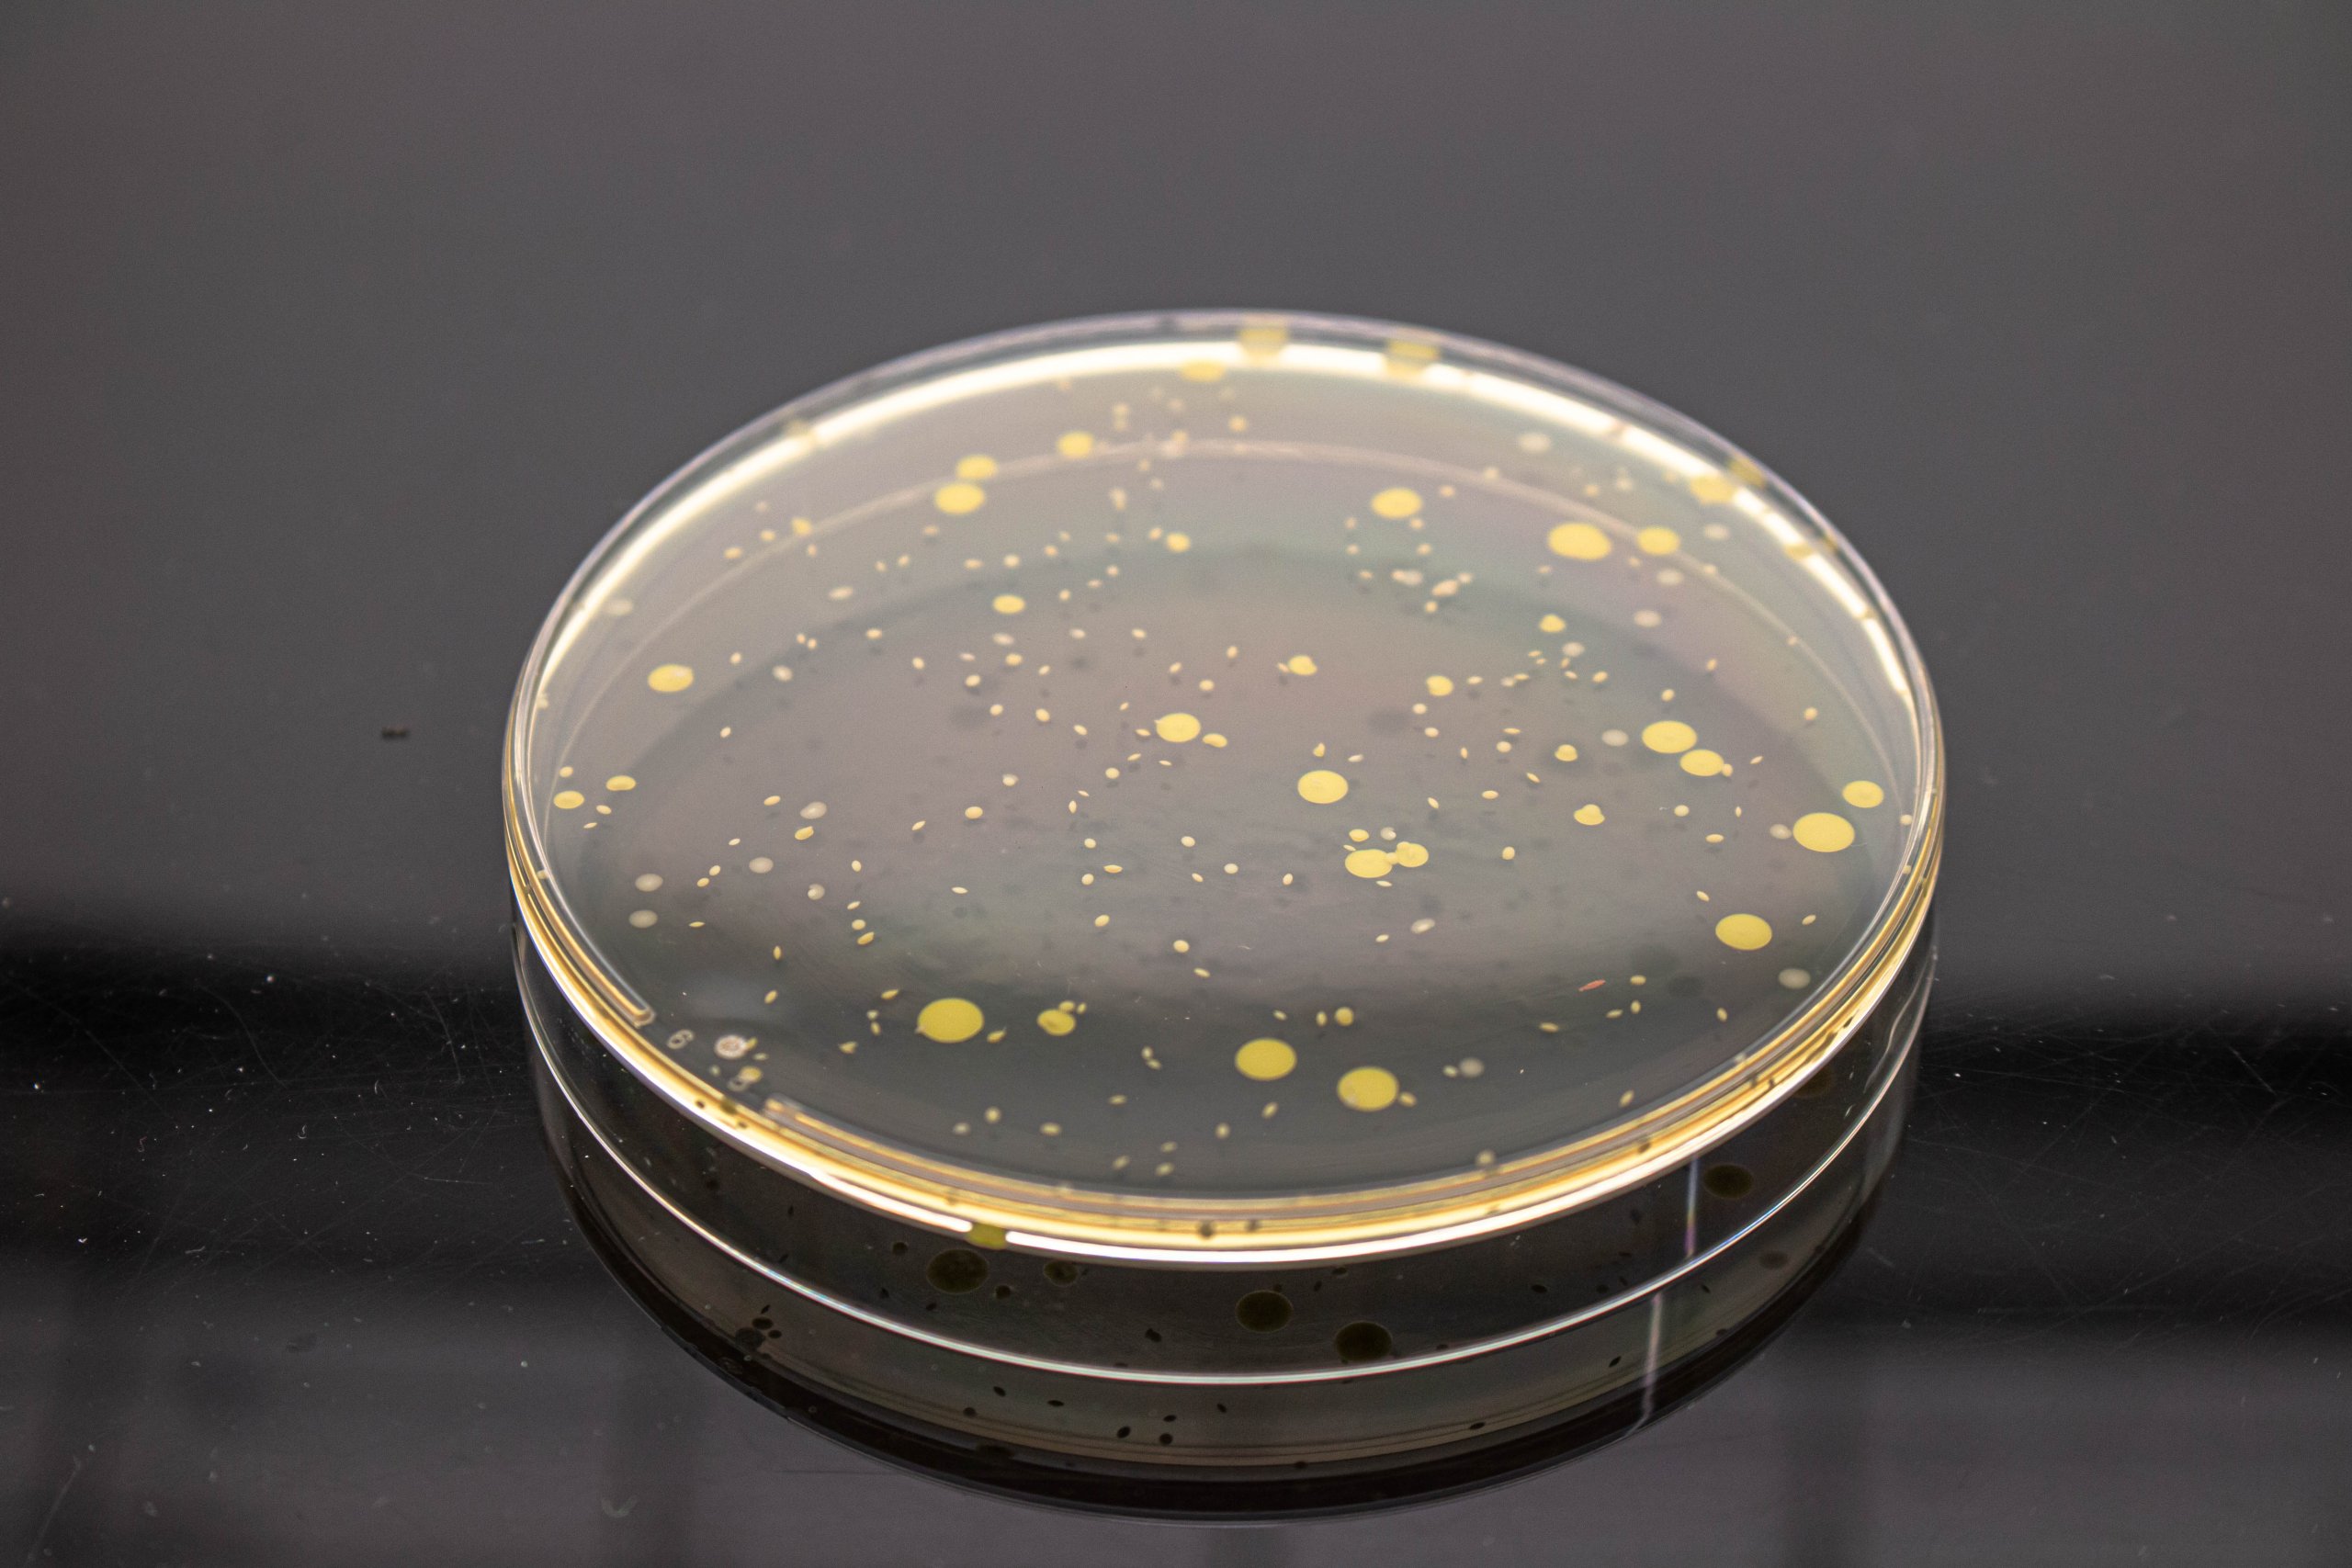
Μικροβιολογικές Αναλύσεις Φαρμάκων, μικροβιολογικές αναλύσεις επιφανειών, υγιεινή επιφανειών αναλύσεις, εργαστήριο αναλύσεων φαρμάκων

Μικροβιολογικές Δοκιμές για Φαρμακευτικά Προϊόντα
Το εργαστήριο QACS παρέχει ένα πλήρες φάσμα από Μικροβιολογικές Αναλύσεις Φαρμάκων για την υποστήριξη της φαρμακευτικής βιομηχανίας. Οι υπηρεσίες διασφαλίζουν την ασφάλεια των προϊόντων και τη συμμόρφωση με τους κανονιστικούς κανόνες προσφέροντας αυστηρούς ελέγχους για παθογόνα και επιβλαβείς μικροοργανισμούς. Χρησιμοποιούμε επαληθευμένες μεθόδους και συμμορφωνόμαστε με τα παγκόσμια πρότυπα, συμπεριλαμβανομένων των USP, EP και JP, για να διασφαλίσουμε την ακρίβεια και την αξιοπιστία σε κάθε δοκιμή.
Οι Μικροβιολογικές Αναλύσεις Φαρμάκων από την QACS Lab επεκτείνονται πέρα από τις συνήθεις αναλύσεις.
Περιλαμβάνουν προσαρμοσμένες μελέτες για την επικύρωση μεθόδων, την αποτελεσματικότητα της συντήρησης και δοκιμές σταθερότητας. Προσφέρουμε επίσης υπηρεσίες περιβαλλοντικής παρακολούθησης (EMP, Environmental Monitoring Program) προσαρμοσμένες σε φαρμακευτικά περιβάλλοντα παραγωγής, διασφαλίζοντας ότι η εγκατάστασή σας συμμορφώνεται με τους κανονισμούς GMP μέσω τακτικών αξιολογήσεων και λύσεων διαχείρισης κινδύνων.
Διασφαλίζουμε την ποιότητα και την ασφάλεια των φαρμακευτικών προϊόντων, πρώτων υλών και νερού (PW, WFI) σε κάθε στάδιο της παραγωγικής διαδικασίας, πραγματοποιώντας Μικροβιολογικούς Ελέγχους Καταμέτρησης (Συνολικός Αριθμός Αερόβιων Μικροβίων, Συνολικός Αριθμός Ζυμών και Μυκήτων) και Έλεγχο για ανεπιθύμητους μικροοργανισμούς, χρησιμοποιώντας μεθόδους USP, EP και JP.
Οι Μικροβιολογικές Αναλύσεις Φαρμάκων διασφαλίζουν ότι οι πρώτες ύλες πληρούν αυστηρά ποιοτικά πρότυπα, ελαχιστοποιώντας τον κίνδυνο επιμόλυνσης και διασφαλίζοντας την ασφάλεια του τελικού προϊόντος. Κύριες υπηρεσίες περιλαμβάνουν:
- EP 2.6.12 & USP <61> Μικροβιολογικοί Έλεγχοι Καταμέτρησης: Περιλαμβάνουν Συνολικό Αριθμό Αερόβιων Μικροβίων (TAMC) και Συνολικό Αριθμό Ζυμών και Μυκήτων (TYMC).
- EP 2.6.13 & USP <62> Δοκιμές για Προσδιορισμένους Οργανισμούς: Ανίχνευση συγκεκριμένων μικροοργανισμών όπως Escherichia coli, Staphylococcus aureus, Pseudomonas aeruginosa και Salmonella,
- USP <60> Δοκιμή Συμπλέγματος Burkholderia cepacia: Διασφάλιση ότι τα μη στείρα προϊόντα πληρούν τα πρότυπα ασφαλείας.
- Δοκιμές Προβιοτικών (USP <64>): Πλήρεις δοκιμές για προβιοτικά προϊόντα για τη διασφάλιση της βιωσιμότητας και της ασφάλειας.
- USP <2021> & USP <2022>: Μικροβιολογικοί Έλεγχοι Ανίχνευσης & Καταμέτρησης μικροοργανισμών σε διατροφικά και διαιτητικά συμπληρώματα, για την επιβεβαίωση της απουσίας μικροβίων και συγκεκριμένων παθογόνων.
Το εργαστήριο της QACS προσφέρει ολοκληρωμένες δοκιμές για παθογόνα και ταυτοποίηση μικροοργανισμών, σύμφωνα με την πιστοποίηση GMP, για την ανίχνευση και εξάλειψη επιβλαβών μικροοργανισμών στα φαρμακευτικά προϊόντα.
Οι προηγμένες μέθοδοι ταυτοποίησης με μοριακές τεχνικές (Real time PCR – 16s αλληλούχιση) βοηθούν στον εντοπισμό πιθανών επιμολυντών, διασφαλίζοντας ότι τα προϊόντα σας είναι απαλλαγμένα από παθογόνα όπως Enterobacter gergoviae, Burkholderia cepacia, Escherichia coli, Pseudomonas aeruginosa ή άλλους ανεπιθύμητους μικροοργανισμούς.
Επιπλέον, ταυτοποιούμε ανεπιθύμητους μικροοργανισμούς που μπορεί να επηρεάσουν την ποιότητα ή την ασφάλεια του προϊόντος. Με την τεχνολογία αιχμής (Next Generation Sequencing) και την τεχνογνωσία μας, παρέχουμε ταχύτατα (εντός 48 ωρών) και ακριβή αποτελέσματα για την ταυτοποίηση βακτηρίων και μυκήτων για να υποστηρίξουμε τα προγράμματα ελέγχου ποιότητας, περιβαλλοντικής παρακολούθησης ή άλλες ανάγκες σας.
Προσφέρουμε υπηρεσίες δοκιμών καταλληλότητας μικροοργανισμών ως μέρος της διαδικασίας επικύρωσης μεθόδου, διασφαλίζοντας ότι οι μικροβιολογικές μέθοδοι είναι κατάλληλες για την ανάλυση των συγκεκριμένων προϊόντων σας.
Αυτές οι προπαρασκευαστικές δοκιμές είναι κρίσιμες για την επικύρωση μεθόδων για δοκιμές στειρότητας, μικροβιολογικών ορίων και ανίχνευση παθογόνων. Οι ειδικοί μας συνεργάζονται μαζί σας για να προσαρμόσουν μελέτες επικύρωσης που να ευθυγραμμίζονται με τους κανονισμούς GMP και να πληρούν τις κανονιστικές απαιτήσεις, διασφαλίζοντας ότι οι μέθοδοι ανάλυσης σας είναι αξιόπιστες και ασφαλείς.
Η αποτελεσματικότητα των συντηρητικών στα φαρμακευτικά και καλλυντικά προϊόντα σας. Σύμφωνα με τις οδηγίες της Ευρωπαϊκής Φαρμακοποιίας 5.1.3 ή της USP <51>, αξιολογούμε την ικανότητα του συντηρητικού σας να αποτρέπει την ανάπτυξη μικροβίων κατά τη διάρκεια της διάρκειας ζωής του προϊόντος. Η αποτελεσματικότητα των συντηρητικών (PET) επιβεβαιώνεται όταν παρατηρείται σημαντική μείωση ή μηδενική αύξηση μικροοργανισμών στο εμβολιασμένο δείγμα υπό συγκεκριμένες θερμοκρασίες και χρονικές συνθήκες. Αυτή η δοκιμή είναι κρίσιμη για προϊόντα όπως κρέμες, αλοιφές και υγρά σκευάσματα, όπου η μικροβιακή μόλυνση θα μπορούσε να υπονομεύσει την ασφάλεια και την αποτελεσματικότητα του προϊόντος.
Εμπιστευτείτε την QACS για την παροχή λεπτομερών και συμμορφούμενων δοκιμών αποτελεσματικότητας συντηρητικών για να υποστηρίξετε τη σταθερότητα και την ασφάλεια του προϊόντος σας. Κύρια Πρωτόκολλα για την αξιολόγηση της αποτελεσματικότητας των συντηρητικών σε φαρμακευτικά προϊόντα:
- EP 5.1.3 Αποτελεσματικότητα Αντιμικροβιακής Συντήρησης
- USP <51> Δοκιμή Αντιμικροβιακής Αποτελεσματικότητας
Οι υπηρεσίες του Περιβαλλοντικού Προγράμματος Παρακολούθησης (EMP) μας διασφαλίζουν ότι το περιβάλλον παραγωγής σας παραμένει συμμορφούμενο με τα πρότυπα GMP.
Προσφέρουμε τακτικές δοκιμές αέρα, επιφανειών και υδάτινων συστημάτων για την ανίχνευση μικροβιακών μολύνσεων, καθώς και ανάλυση επιφανειακών δειγμάτων για συγκεκριμένους μικροοργανισμούς. Οι υπηρεσίες EMP μας βοηθούν στον εντοπισμό και τη μείωση των κινδύνων μόλυνσης, διασφαλίζοντας ένα στείρο και ελεγχόμενο περιβάλλον παραγωγής που συμμορφώνεται με τις κανονιστικές απαιτήσεις. Συνεργαζόμαστε στενά μαζί σας για να σχεδιάσουμε ένα EMP προσαρμοσμένο στις ανάγκες της εγκατάστασής σας, υποστηρίζοντας τη συνεχή συμμόρφωση με τους κανονισμούς GMP.
Στην QACS, προσφέρουμε εξειδικευμένες υπηρεσίες δοκιμών προσαρμοσμένες στις αυστηρές απαιτήσεις των οφθαλμικών προϊόντων που συσκευάζονται σε σύστημα πολλαπλών δόσεων με κλείσιμο άκρης, το οποίο αποτρέπει την ανάγκη χρήσης συντηρητικών, για να διασφαλιστεί η ασφάλεια και η αποτελεσματικότητα τους. Η εμπειρογνωμοσύνη μας περιλαμβάνει πλήρεις δοκιμές, όπως:
- Δοκιμή Δυναμικής Μικροβιολογικής Πρόκλησης Χειρότερης Περίπτωσης για συστήματα συσκευασίας. Αυτή η κρίσιμη μελέτη παρέχει τεκμηριωμένη απόδειξη ότι τα οφθαλμικά προϊόντα χωρίς συντηρητικά, ακόμη και υπό ακραίες συνθήκες, μπορούν να προστατεύσουν την πρώτη δόση που παραδίδεται και να αποτρέψουν τη μόλυνση του περιεχομένου του προϊόντος.
Δοκιμάζουμε διάφορα δοχεία για να διασφαλίσουμε την επαναληψιμότητα και χρησιμοποιούμε μονο-στελεχιακά ή πολύ-στελεχιακά αιωρήματα μικροοργανισμών που συχνά σχετίζονται με οφθαλμικές λοιμώξεις ή μικροβιακές μολύνσεις ανθρώπινης χλωρίδας. Ο σχεδιασμός της μελέτης προσαρμόζεται ανά προϊόν, βασισμένος στη διάρκεια ζωής και το σχήμα δοσολογίας του προϊόντος. Αυτή η μελέτη είναι κρίσιμη για την επιβεβαίωση ότι το σύστημα κλεισίματος διατηρεί την ακεραιότητα του προϊόντος καθ’ όλη τη διάρκεια ζωής και του σχήματος δοσολογίας του.
- Μελέτες αποτελεσματικότητας για να τεκμηριωθεί ότι το σύστημα κλεισίματος δεν προάγει τον σχηματισμό βιοφίλμ. Η μελέτη μικροβιολογικής πρόκλησης επιβεβαιώνει ότι τα οφθαλμικά προϊόντα που συσκευάζονται σε σύστημα πολλαπλών δόσεων δεν προάγουν την ανάπτυξη βιοφίλμ στην επιφάνεια του στομίου. Αυτές οι μελέτες αξιολογούν την έκθεση του στομίου σε στατικά βιοφίλμ χρησιμοποιώντας συχνά αναφερόμενα βακτήρια σχηματισμού βιοφίλμ και είναι απαραίτητες για την καταχώριση αυτών των προϊόντων.
Το εργαστήριό μας προσφέρει δοκιμές σύμφωνα με το πρότυπο ASTM F1608-21, μία διεθνώς αναγνωρισμένη μέθοδο αξιολόγησης της ικανότητας πορωδών υλικών συσκευασίας (όπως αυτά που χρησιμοποιούνται στη στείρα συσκευασία ιατροτεχνολογικών προϊόντων) να εμποδίζουν τη διέλευση αερομεταφερόμενων βακτηρίων.
Γιατί είναι σημαντικό
Η συσκευασία στείρων ιατροτεχνολογικών προϊόντων οφείλει να λειτουργεί ως μικροβιακός φραγμός, προστατεύοντας το αποστειρωμένο περιεχόμενο από επιμόλυνση έως τη στιγμή του ανοίγματος.
Τα πορώδη υλικά συσκευασίας (π.χ. nonwovens, σακουλάκια αποστείρωσης, φιλμ φραγμού κ.ά.) επιτρέπουν τη διείσδυση των παραγόντων αποστείρωσης (όπως οξείδιο του αιθυλενίου, ατμός), ενώ ταυτόχρονα πρέπει να αποτρέπουν την είσοδο μικροοργανισμών. Το ASTM F1608 αποτελεί βασική μέθοδο για την παροχή ποσοτικών δεδομένων σχετικά με αυτή τη προστατευτική ικανότητα.